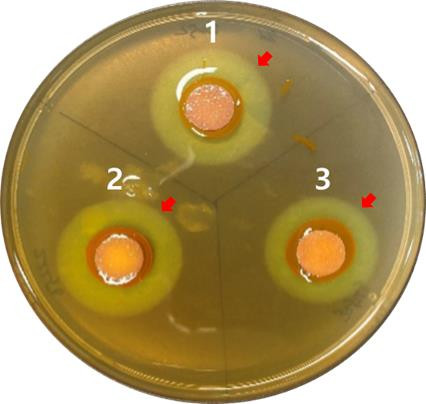

|
국립해양생물자원관, 태안 갯벌서 신종 미생물 발견
알긴산 분해 효소 보유, 해양바이오 소재 활용 기대
영남도민일보 기자 / yndm1472@nate.com 입력 : 2026년 02월 15일(일) 21:01
공유 :   
|
|
| | | | ↑↑ 염색 시약 반응 결과, 신종 미생물(1번)이 대조군 미생물(2, 3번)과 동일하게 알긴산을 분해하여 주변에 선명한 분해환(Clearance zone, 화살표 표시)이 형성된 것을 확인할 수 있다. | | ⓒ (주)영남도민일보 | | [영남도민일보] 영남도민일보 기자 = 국립해양생물자원관은 충남 태안 갯벌에서 해조류 성분인 알긴산을 분해할 수 있는 신종 해양미생물 ‘아가리보란스 세디미니스’를 발견했다고 밝혔다.
알긴산은 식품·의약·화장품에 활용되는 소재로 이번에 발견된 미생물은 다시마와 미역 등 갈조류에 포함된 알긴산을 분해해 항산화와 면역 기능에 관련된 알긴산 올리고당을 만드는 것이 특징이다.
연구진은 미생물이 발견된 환경을 반영해 ‘퇴적물 유래’라는 의미의 이름을 붙였으며, 이번 연구 결과는 국제 미생물 분야 학술지에 실려 학술적 가치도 인정받았다.
김현태 자원관장은 “우리 갯벌에는 산업적으로 활용할 수 있는 미생물 자원이 풍부하다”며 “앞으로도 새로운 해양미생물을 찾아 해양바이오 소재 개발로 이어가겠다”고 말했다.
|
|
|
영남도민일보 기자 yndm1472@nate.com - Copyrights ⓒ(주)영남도민일보.
무단 전재 및 재배포 금지 -
|
|
|
|
|
|
|
|
|
실시간
많이본
뉴스
|
|
|
|
최신뉴스
|
|
|
유정근 영주시장 예비후보,“영주~풍기 폐철도, 영주경제 .. |
영주시, 제5기 아동참여위원회 발대식 및 아동권리교육 개.. |
영주시, 2026년 서울시 「넥스트로컬 8기」 사업 참여.. |
영주시청소년상담복지센터, 청소년 보호 위한 상담자 교육 .. |
영주시, 무빙 플레이버스(Play Bus) 확대 운영으로.. |
영주시, 재난 예방 위한 집중안전점검 나선다.. |
제46회 영주시 장애인의 날 기념식 성황리에 개최.. |
영주시, ‘신이 된 왕자, 뮤지컬 「금성대군」 공연 개최.. |
봉화군, 2026년 약용버섯 재배 실용교육 과정 운영.. |
봉화군,‘일자리와 마음을 함께 지킨다’기관 간 자살예방 .. |
소천초병설유, 짐스 오감 놀이 체험.. |
국립산림치유원, 바쁜 일상 잠시 멈춤...숲에서 보내는 .. |
영주적십자병원, 2026년 다문화가정 아동 건강검진 지원.. |
영주시노인복지관, “효(孝)의 가치를 글로 담다.. |
영주시, 기계설비 유지관리자 선임기준 충족·통보 이행 당.. |
|